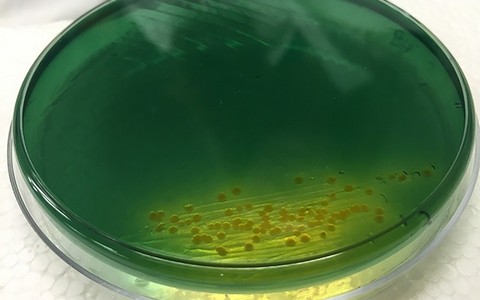
Kooleratekitaja Vibrio cholerae

Graafik: enim viidatud Tartu ülikooli teadlased ja valdkonnad (0)

Üle poole Eesti teaduspublikatsioonidest avaldatakse Tartu ülikooli teadlaste poolt. Allpool toodud graafikutelt leiab enim tsiteeritud teadlased ning teadusvaldkonnad, samuti võrdluse naaberriikidega.
Toimetaja: Kristjan Jung, Tartu ülikool